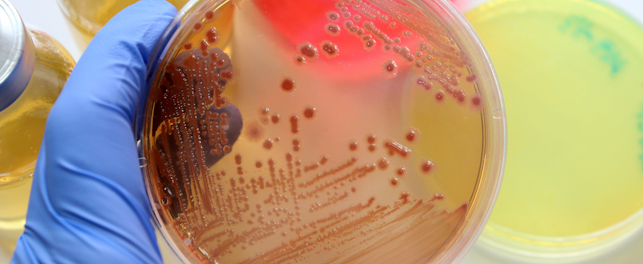
Standardy i certyfikacja podłoży mikrobiologicznych mają wpływ na jakość wyników badań.

Z radością ogłaszamy, że nasz dział Health & Nutrition po raz kolejny uzyskał prestiżowy certyfikat Dobrej Praktyki Laboratoryjnej! Serdecznie gratulujemy wszystkim zaangażowanym w ten proces, którzy poprzez swój trud i profesjonalizm przyczynili się do osiągnięcia tego ważnego kroku.
Inspekcje Biura ds. Substancji Chemicznych przeprowadzone zostały w 3 stacjach badawczych SGS Polska: w Ołtarzewie, Wenecji i Marszowicach. Wszystkie zakończyły się z pozytywnymi wynikami, które zapewniły nam certyfikat DPL w zakresie badania zachowania się badanej substancji w wodzie, glebie i powietrzu, badania bioakumulacji (część polowa) oraz badania pozostałości (część polowa).
Certyfikat Dobrej Praktyki Laboratoryjnej jest wyrazem naszego zobowiązania do utrzymywania najwyższych standardów jakości i bezpieczeństwa w naszych stacjach polowych. To też potwierdzenie, że nasze procedury, sprzęt i personel spełniają rygorystyczne normy określone w międzynarodowych standardach. Ponadto jest on gwarancją dla naszych klientów, że każdy proces badawczy prowadzony w naszych jednostkach polowych jest wykonywany zgodnie z najnowszymi normami i najlepszymi praktykami branżowymi. Certyfikat ten potwierdza, że nasze wyniki są wiarygodne, rzetelne i zgodne z najwyższymi standardami jakości.
Jesteśmy przekonani, że ponowne uzyskanie tego certyfikatu wpłynie pozytywnie na naszą reputację jako niezawodnego partnera biznesowego. Dzięki niemu zyskujemy również możliwość poszerzenia naszej oferty i obsługi nowych projektów, co przyczyni się do dalszego wzrostu naszej firmy.
Dziękujemy wszystkim zaangażowanym za ich ciężką pracę i profesjonalizm, który przyczynił się do tego ważnego osiągnięcia. Jesteśmy dumni z naszego zespołu i gotowi do dalszego podnoszenia jakości naszych usług.
O SGS
Jesteśmy SGS – światowym liderem w dziedzinie badań, inspekcji i certyfikacji, uznawanym za wzorzec w zakresie zrównoważonego rozwoju, jakości i rzetelności. W sieci ponad 2650 oddziałów i laboratoriów zatrudniamy przeszło 98 000 pracowników, którzy poprzez wspólną pracę umożliwiają lepszy, bezpieczniejszy i bardziej połączony świat.
.cdn.pl-PL.1.png?fit=crop&auto=format&crop=focal point&w=643&h=264)